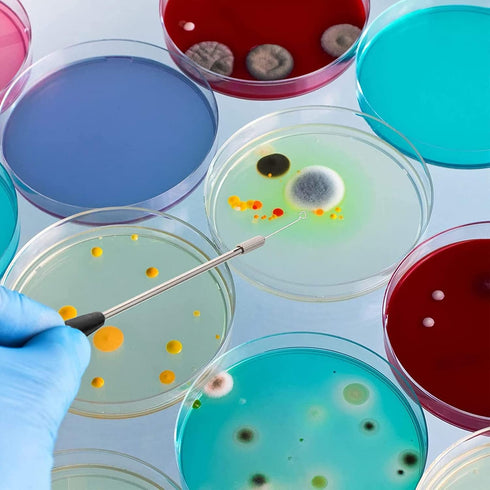
23cm Inoculation Loop Inoculation Rod Lightweight Coating Inoculation Rod Set Mycology Reusable Inoculation Loop Kit for Laboratory Lab...

23cm Inoculation Loop Inoculation Rod Lightweight Coating Inoculation Rod Set Mycology Reusable Inoculation Loop Kit for Laboratory Lab
Clean and Hygienic: These inoculation rings are fitted with plastic cylindrical tubes to isolate the air and to avoid prolonged exposure to the air, which can cause contamination and compromise use.
Sufficient Quantity: You will receive 2 inoculation rods of 23cm in length and a total of 90 interchangeable rings.
Chrome Plated Surface: The inoculation rods are made of copper with a chrome plated surface. The chrome layer effectively ensures the copper from oxidation to copper green and is .
Small Size: These inoculation tools are lightweight and small, with a firm one handed grip for fast and efficient handling.
Simple to Change: Changing inoculation rings is also very simple, whether in the laboratory or in classroom applications, and the rings with storage tubes are easy to carry.
- FREE standard shipping within the United States(3-6 Days)on all orders!
- 100% money back guarantee for items not delivered or damaged during shipping.
- Safe and secure checkout with our high quality encryption
- Shipping services: UPS, FedEx, USPS.
- Only ship to the lower 48 states, no APO/FPO addresses or PO Boxes allowed.
- Local pickups and combined shipping options are not provided at this time.
- You can return a product for up to 30 days from the date you purchased it.
- Any product you return must be in the same condition you received it and in the original packaging. Please keep the receipt.
- A full refund if you don’t receive your order A full refund if your order does not arrive within the guaranteed time (6-7 business days not including 1 processing day.)
We accept payment by any of the following methods:
Credit Cards, PayPal, Shop Pay, Apple Pay, Google Pay, Amazon Pay, Meta Pay
Customer satisfaction is very important to us.
If you have any problem with your order, please contact us and we will do our best to make you satisfied.
If you have any queries, please contact us via
Support@ZeeBooth.com
We usually respond within 24 hours on weekdays.